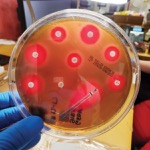

By Gina Shaw
Three promising new rapid infectious disease diagnostic assays took the stage at IDWeek 2024, in Los Angeles, including the PhAST blood culture gram-negative (BC GN) assay, deepull UllCORE BSI Test and Day Zero Diagnostics (DZD) Pathovate ultra-high enrichment (UHE).

PhAST’s BC GN assay is a rapid phenotypic antimicrobial susceptibility test (AST) for bloodstream infections (BSIs), which generates results within 90 minutes using microscopy videos of patient samples; deepull’s UllCORE BSI Test is a direct-from-blood multiplex polymerase chain reaction (PCR) test targeting 95% of BSI/sepsis-causing pathogens and associated resistance determinants; and DZD’s Pathovate UHE offers pathogen whole-genome sequencing for rapid identification and AST directly from multiple clinical sample types.
For many patients with suspected sepsis, earlier phenotypic testing is needed for definitive therapy indications, said Sankha “Bobby” Basu, MD, PhD, PhAST’s chief medical officer. “At a lot of institutions, a molecular platform is used, which identifies the organism and tests for a handful of antimicrobial resistance genes. When no resistance genes are detected, gram-positive coverage can be discontinued, but at a lot of institutions, it is thought to be too risky to narrow the antibiotics because the current genetic information doesn’t give all of the resistance mechanisms. And so the patient remains on broad-spectrum therapy until the organism is subcultured.”
PhAST aims to change that with the BC GN assay, which uses single-cell microscopy powered by artificial intelligence to analyze bacterial motility and morphological changes for predicting resistance, providing rapid phenotypic AST results for BSIs within approximately 90 minutes. “Although we are an in vitro diagnostic, our goal is to provide the most in vivo–like conditions—essentially single-cell microscopy looking directly at a clinical sample for morphological features and other variables that we use to predict resistance and susceptibility of these organisms,” Dr. Basu said. “The whole process is relatively easy with minimal hands-on time, which we think is quite important with how busy microbiology labs currently are,” he said.
The assay covers some 10,000 bug–drug combinations and more than 93% of gram-negative organisms responsible for BSIs, Dr. Basu said, with 93.3% categorical agreement and a very major error rate of only 1.4%.
“These are all within the FDA acceptability criteria of 90% for categorical agreement and less than 2% for very major errors.”
deepull’s Sepsis Diagnostic
Kimberle Chapin-Robertson, MD, the chief medical officer for deepull, presented preliminary data on the company’s new sepsis diagnostic, UllCORE BSI, a direct-from-blood multiplex PCR test, indicating that it detects approximately 95% of BSIs and sepsis-causing pathogens along with associated resistance determinants, with a turnaround time of about one hour. The goal is to enable rapid transition from broad-spectrum empiric therapy to pathogen-directed therapy, Dr. Chapin-Robertson said. The assay utilizes a benchtop instrument that can process small sample volumes, making it suitable for both pediatric and adult patients.
She noted that current standard-of-care blood culture assays have multiple limitations, including diagnostic sensitivity. “I’m going to be generous and say that we identify the pathogen in 50% of patients that have BSI or sepsis,” she said. “Contamination management is another major issue; about 40% of our positive blood cultures are actually some type of contaminant. Infection is seldom confirmed microbiologically when treatment is started; even when microbiological tests are completed, culture-positive sepsis is observed in only 30% to 40% of cases.” Other limitations, she added, include variable time to result and cumbersome laboratory workflow.
In preliminary clinical data using prospectively collected blood samples from 108 patients presenting to the emergency department (ED) with sepsis, the UllCORE BSI test detected 60 specimens out of 64 positive blood cultures, for 94% positive agreement. An additional 23 detections occurred using the test among patients who had tested negative on blood culture.
“Reviewing empiric therapy initiated at the time of blood culture, a high percentage of changes could have been done to optimize therapy, including escalation to appropriate antibiotic, for example, ertapenem being given for Enterococcus faecium; de-escalation for unnecessary antibiotic, such as vancomycin with no Staph isolated; and optimization, such as piperacillin-tazobactam changed to penicillin for Streptococcus pneumoniae,” she said.
DZD’s Pathovate Whole-Genome Sequencing for Rapid ID and AST
Pathovate UHE from DZD uses a UHE process to isolate bacterial DNA from blood samples, significantly increasing the ratio of bacterial DNA to human DNA and achieving near whole-genome coverage with rapid species identification and AST results within six to eight hours, reported Doug Kwon, MD, PHD, DZD’s co-founder; a physician scientist at the Ragon Institute of Mass General, MIT and Harvard, in Cambridge, Mass.; and the director of clinical operations at the Ragon Institute.
“The UHE process massively depletes the human DNA in a blood sample, collects the small number of bacterial and fungal cells that are present, amplifies those genomes, and then provides rapid whole-genome sequences,” he said. “The process yields 1,000 times more pathogen data with four times less sequencing than the cfDNA [cell-free DNA] approach, providing on average 98% coverage of the whole genome.” Machine learning algorithms are employed to generate accurate antibiotic susceptibility predictions.
In an unpublished research and development clinical study, RAPPID, DZD accrued data on 225 ED patients with suspected bacteremia. “In parallel, we sent the samples through the standard microbiology blood culture process, and through the DZD UHE process,” Dr. Kwon explained.
Out of the 20 blood culture–positive samples that were found, Pathovate demonstrated 80% sensitivity, 99.9% specificity and 99.8% overall agreement. “We also did a subset analysis because of some of the differences between what happens with the sample that goes to a clinical microbiology lab versus a sample that we get at the company,” Dr. Kwon said. “Limiting analysis to the 17 samples with a DZD in-house culture-positive pathogen, we had 94% sensitivity and 100% specificity, with no false-positive results.” For antibiotic susceptibility calls, they demonstrated 92% categorical agreement with the microbiology lab.
Dr. Basu reported that he holds stocks/bonds in PhAST. Dr. Chapin-Robertson reported an ownership interest in deepull. Dr. Kwon reported that he is a co-founder and consultant for Day Zero Diagnostics.